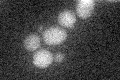
YJR122W
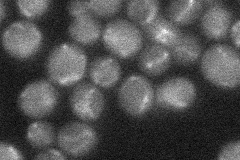
YJR122W

View description
Mitochondrial matrix protein involved in the incorporation of iron-sulfur clusters into mitochondrial aconitase-type proteins; activates the radical-SAM family members Bio2p and Lip5p; interacts with Ccr4p in the two-hybrid system
Localization:
Intensity:
Fold change:
Significance:
-
C’ GFP library in SD
below threshold16.16 -
N' NOP1pr-GFP in SD

mitochondria38.6153 -
N' TEF2pr-mCherry in SD

mitochondriaN/A -
N' NATIVEpr-GFP in SD
mitochondria20.7607 -
N' TEF2pr-VC and Cyto-VN in SD

#N/A0 -
C’ GFP library in SD+DTT

cytosol17.551.08No -
C’ GFP library in SD+H2O2

cytosol16.050.99No -
C’ GFP library in Starvation Media

cytosol18.171.12No -
C’ GFP library on the background of Pup2-DaMP

below threshold -
C’ GFP library on the background of CCT mutant

below threshold15.96070.987478No
